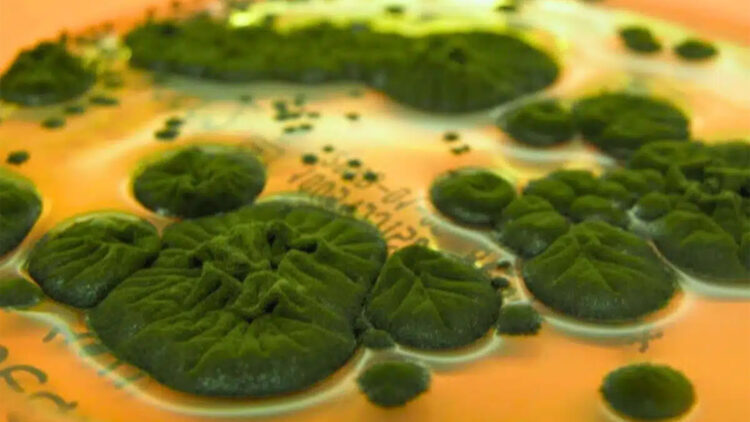
Researchers confirm that a fungus in Chernobyl could use radiation as an energy source, changing everything we knew 1 Researchers confirm that a fungus in Chernobyl could use radiation as an energy source, changing everything we knew

The Chernobyl Nuclear Power Plant explosion happened nearly 40 years ago, but the exclusion zone is still dangerous for people. Nature, however, never ceased. Microbes have returned, along with plants and animals. One of the most peculiar survivors is a tiny, velvety black fungus that seems to thrive in radiation.
Cladosporium sphaerospermum is the name of the fungus that has been discovered adhering to the walls of some of the most radioactive buildings surrounding the destroyed reactor. Melanin, its dark pigment, could be the key—according to scientists—by assisting the fungus in using ionizing radiation in a way similar to how plants use sunlight for photosynthesis, based to the theory. They have even named this process radiosynthesis.
However, no one has demonstrated yet that radiosynthesis actually exists. Scientists are certain that this fungus is persisting—maybe even flourishing—in an environment designed to be dangerous. One of the most fascinating unanswered questions in contemporary biology is how it does that.
A black fungus in a radioactive shelter
The Chernobyl Exclusion Zone was investigated by microbiologist Nelli Zhdanova and her group from the Ukrainian National Academy of Sciences in the late 1990s. They imagined very little life within the highly contaminated shelter surrounding the destroyed reactor. But in fact, they discovered a community of fungi, with 37 species. Many were melanin-rich and dark brown or black.
Among the dominant species, Cladosporium sphaerospermum was found to have some of the highest levels of radioactive contamination in the samples. This fungus was subsequently exposed to ionizing radiation in the laboratory by immunologist Arturo Casadevall and radiopharmacologist Ekaterina Dadachova at the Albert Einstein College of Medicine. It appeared strangely resistant to damage, even improving in the presence of radiation, unlike most living things.
Atoms can lose electrons due to the energy of ionizing radiation. In the real world, that can shred DNA, break molecules, and interfere with chemical reactions. This is the reason it can be used to destroy cancer cells and why it represents such a threat to human health. However, this fungus seems to be able to manage it quite well.
The strange idea of radiosynthesis
Dadachova and Casadevall proposed in 2008 that the process happening in C. sphaerospermum looked similar to photosynthesis. Melanin in the fungus seemed to be absorbing energy and assisting in its transformation into something beneficial, much like chlorophyll in plants. Melanin can also act as a barrier, shielding the fungus from radiation’s most damaging effects.
Later, in 2022, researchers launched C. sphaerospermum into orbit and affixed it to the International Space Station’s exterior. When exposed to high levels of cosmic radiation, it blocked more radiation than a control dish free of fungus. That experiment mainly tested its potential as a natural shield for space missions.
Researchers have not demonstrated that the fungus is clearly obtaining energy from ionizing radiation or fixing carbon as a result of it. According to a Stanford University team headed by engineer Nils Averesch, “Actual radiosynthesis, however, remains to be shown, let alone the reduction of carbon compounds into forms with higher energy content or fixation of inorganic carbon driven by ionizing radiation.”